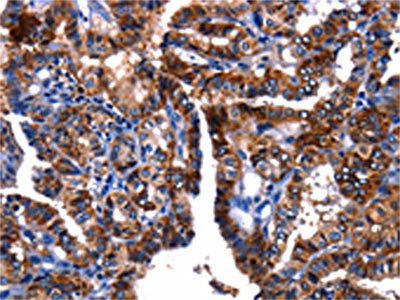

GIP Antibody
-
中文名稱:GIP兔多克隆抗體
-
貨號:CSB-PA095417
-
規(guī)格:¥1100
-
圖片:
-
其他:
產(chǎn)品詳情
-
Uniprot No.:
-
基因名:
-
別名:Gastric Inhibitory Peptide antibody; Gastric inhibitory polypeptide antibody; Gastric inhibitory polypeptide precursor antibody; GIP antibody; GIP_HUMAN antibody; Glucose dependent insulinotropic polypeptide antibody; Glucose-dependent insulinotropic polypeptide antibody; Incretin hormone antibody
-
宿主:Rabbit
-
反應(yīng)種屬:Human
-
免疫原:Fusion protein of Human GIP
-
免疫原種屬:Homo sapiens (Human)
-
標(biāo)記方式:Non-conjugated
-
抗體亞型:IgG
-
純化方式:Antigen affinity purification
-
濃度:It differs from different batches. Please contact us to confirm it.
-
保存緩沖液:-20°C, pH7.4 PBS, 0.05% NaN3, 40% Glycerol
-
產(chǎn)品提供形式:Liquid
-
應(yīng)用范圍:ELISA,IHC
-
推薦稀釋比:
Application Recommended Dilution ELISA 1:1000-1:5000 IHC 1:25-1:100 -
Protocols:
-
儲存條件:Upon receipt, store at -20°C or -80°C. Avoid repeated freeze.
-
貨期:Basically, we can dispatch the products out in 1-3 working days after receiving your orders. Delivery time maybe differs from different purchasing way or location, please kindly consult your local distributors for specific delivery time.
-
用途:For Research Use Only. Not for use in diagnostic or therapeutic procedures.
相關(guān)產(chǎn)品
靶點詳情
-
功能:Potent stimulator of insulin secretion and relatively poor inhibitor of gastric acid secretion.
-
基因功能參考文獻:
- The genetic variability of GIP gene is associated with coronary artery disease and it may play a role in the premature coronary artery disease in the Chinese Han population with type 2 diabetes. PMID: 29765988
- The ability of a truncated form of GIP, GIP(3-30)NH2, to antagonize the physiological actions of GIP in glucose metabolism, subcutaneous abdominal adipose tissue blood flow, and lipid metabolism in humans. PMID: 28667118
- GIP and PP plasma concentrations are lower in pancreatic cancer irrespective of the degree of glucose intolerance as compared to Type 2 diabetic patients and healthy controls. PMID: 28027898
- Evening postprandial insulin and GIP responses and insulin resistance declined by over 30% after three meals that limited daily carbohydrate intake to 30% compared to no such changes after three 60%-carbohydrate meals, an effect that was independent of pre-meal exercise. PMID: 27798656
- the stimulatory effect of IGF-1 on GIP promoter support the hypothesis of a functional growth hormone-igf-1-GIP axis PMID: 28179449
- decreased maternal 25OHD may be associated with decreased cord 25OHD and increased cord GLP-1 and GIP levels, which may be involved with the transfer of maternal glucose to the fetus PMID: 26650343
- Excess androgen activity might be a factor contributing to alter secretion of incretins in lean polycystic ovary syndrome (PCOS) women. However it could not be ruled out that it is also possible that increased GIP levels might induce hyperandrogenemia in PCOS. PMID: 26895276
- Our results might indicate an altered DPP4-incretin system and altered immunoregulation including a potentially dysfunctional GLP1(9)(-)(36) signaling in T1DM. PMID: 26434625
- Fasting GIP concentrations are higher in individuals with a history of cardiovascular disease (myocardial infarction, stroke) when compared with control subjects. PMID: 26395740
- Data suggest that high levels of blood glucose or AGEs (advanced glycation end products), as seen in hyperglycemia, reduce secretion of insulin by pancreatic beta cells via antagonism of GIP (gastric inhibitory polypeptide)/GIP receptor signaling. PMID: 26221611
- Data confirm that postprandial plasma levels of glucose-dependent insulinotropic polypeptide (GIP) and insulin (INS) are responsive to glycemic index of foods consumed; glycemic index of breakfast cereals regulate plasma postprandial GIP and INS. PMID: 25852025
- irisin and GIP might contribute to the development of polycystic ovary syndrome and may also represent novel polycystic ovary syndrome biomarkers PMID: 25029417
- Data suggest that postprandial blood levels of both GIP and insulin can be regulated by diet; here, inclusion of nopal/Opuntia/cactus (a functional food in traditional Mexican medicine) in breakfast reduces postprandial levels of GIP and insulin. PMID: 25132122
- phosphatidylinositol 3-kinase gamma has a role in insulin secretion induced by glucose-dependent insulinotropic polypeptide PMID: 25288806
- These novel results support the notion that the GIP-GIPR axis plays a role in the etiology of central obesity in humans PMID: 25324507
- Data from studies in healthy Japanese men suggest that plasma GIP levels in postprandial period are dose dependently increased by fat content of meals of ordinary size, despite the amount of additional fat being relatively small. PMID: 24507870
- Patients with idiopathic gastroparesis exhibit abnormal GIP levels. PMID: 23663508
- Beta cell connectedness is an inherent property of human islets that is likely to influence incretin-potentiated insulin secretion. PMID: 24018562
- Data suggest that postprandial plasma levels of glucose-dependent insulinotropic peptide (GIP) and glucagon-like peptide-1 (GLP1) are increased after consumption of buckwheat crackers versus rice crackers in healthy and type 2 diabetic subjects. PMID: 23485142
- GIP induces an inflammatory and prolipolytic response via the PKA -NF-kappaB-IL-1 pathway and impairs insulin sensitivity of glucose uptake in human adipocytes. PMID: 23092914
- results indicate postprandial GIP secretion in early-phase after test meal in Japanese patients with type 2 diabetes was positively correlated with BMI, but not those with type 1 diabetes PMID: 22301939
- Hyperinsulinemia subjects with metabolic syndrome showed increased GIP secretion that could be responsible for the delayed glucagon suppression. PMID: 22391044
- Data suggest that reduced insulinotropic effect of GIP or GLP-1 (as in type 2 diabetes) can be induced in healthy subjects; this indicates that reduced incretin stimulation of insulin secretion results from insulin resistance/glucose intolerance. PMID: 22319034
- GIP reduces free fatty acid release from adipose tissue by inhibition of lipolysis or by increased reesterification. PMID: 22179810
- may have a pro-obesogenic action [review] PMID: 21815989
- Studies identified some potentially important additional C-terminal interactions of GIP with its N-terminal extracellular receptor domain. PMID: 21539943
- We report that the human GIP locus was differentially selected in East Asians about 8100 years ago based on the analysis of a nonsynonymous SNP (rs2291725). PMID: 20978139
- GLP-2, but not GIP, was found to stimulate the release of glucagon in patients with T1DM, suggesting a role for GLP-2 in the postprandial hyperglucagonaemia characterising individuals with T1DM PMID: 20580750
- These results suggest that Tyr/His(1) and Ile/Thr(7) of GIP/GLP-1 peptides confer differential ligand selectivity toward GIPR and GLP1R. PMID: 20799012
- We demonstrate for the first time that changes in insulin secretion after lifestyle intervention may be mediated via alterations in GIP secretion from intestinal K-cells PMID: 20200305
- No statistically significant association was observed between any of the single nucleotide polymorphisms of GIP analysed and type 2 diabetes in our population. PMID: 20673334
- GIP is expressed in and secreted from pancreatic islets and promotes islet glucose competence and also could support islet development and/or survival. PMID: 20138041
- a binding mode of GIP to GIPR in which the N-terminal moiety of GIP was sited within transmembrane helices (TMH) 2, 3, 5, and 6 with biologically crucial Tyr1 interacting with Gln224 (TMH3), Arg300 (TMH5), and Phe357 (TMH6). PMID: 20061446
- Substitution of Glu(3) in GIP with proline produces a novel dipeptidylpeptidase IV-resistant GIP antagonist which inhibits GIP-induced cAMP generation and insulin secretion with high sensitivity and specificity in vitro. PMID: 11820780
- activates the Raf-Mek1/2-ERK1/2 module via a cyclic AMP/cAMP-dependent protein kinase/Rap1-mediated pathway PMID: 12138104
- Mutation in promoter region of gip receptor gene are unlikely to underlie GIP-dependent Cushing syndrome. PMID: 12530694
- Elevated plasma GIP levels are correlated with hyperinsulinemia in the impaired glucose-tolerant state, whereas type 2 diabetes is associated with a failure to secrete adequate amounts of GIP. PMID: 15220248
- bombesin and nutrients additively stimulate GIP release from GIP/Ins cells. PMID: 15383372
- Results describe the solution structure of GIP(1-30)amide, the major biologically active fragment of glucose-dependent insulinotropic polypeptide. PMID: 15522230
- GIP augments glucose-stimulated insulin secretion and acts as an endogenous inhibitor of gastric acid secretion--REVIEW PMID: 15533777
- GIP stimulates insulin secretion by potentiating events underlying membrane depolarization and exerting direct effects on exocytosis. PMID: 15955806
- The relationship between insulin resistance and the insulin secretion to GIP suggests that beta cell secretory function in response to different stimuli increases adaptively when insulin sensitivity is diminished, as in gestational diabetes. PMID: 16010522
- GIP is rapidly degraded into inactive metabolites by the enzyme dipeptidyl-peptidase-IV. (review) PMID: 16142014
- protein kinase B, LKB1, and AMP-activated protein kinase have roles in activation of lipoprotein lipase by glucose-dependent insulinotropic polypeptide in adipocytes PMID: 17244606
- study identified a splice site mutation of the Glucose-dependent insulinotropic polypeptide (GIP) gene which results in a truncated protein and provides evidence for association of GIP receptor genotype with cardiovascular disease PMID: 17624916
- physiologic role for GIP in lipid homeostasis and possibly in the pathogenesis of obesity. PMID: 18054552
- concomitant expression of Pax6 and Pdx1 is important for glucose-dependent insulinotropic polypeptide expression PMID: 18593849
- GIP secretion is blunted after the biliopancreatic diversion only in diabetic patients, suggesting a role in insulin resistance and diabetes. PMID: 19229515
- GIP may mediate the attenuated glucose-stimulated insulin response after exercise/diet interventions PMID: 19351807
- Inhibition of apoptosis by GIP is mediated via a key pathway involving Akt-dependent inhibition of apoptosis signal-regulating kinase 1, which subsequently prevents the pro-apoptotic actions of p38 MAPK and JNK. PMID: 19748889
顯示更多
收起更多
-
亞細胞定位:Secreted.
-
蛋白家族:Glucagon family
-
數(shù)據(jù)庫鏈接:
Most popular with customers
-
-
YWHAB Recombinant Monoclonal Antibody
Applications: ELISA, WB, IHC, IF, FC
Species Reactivity: Human, Mouse, Rat
-
Phospho-YAP1 (S127) Recombinant Monoclonal Antibody
Applications: ELISA, WB, IHC
Species Reactivity: Human
-
-
-
-
-